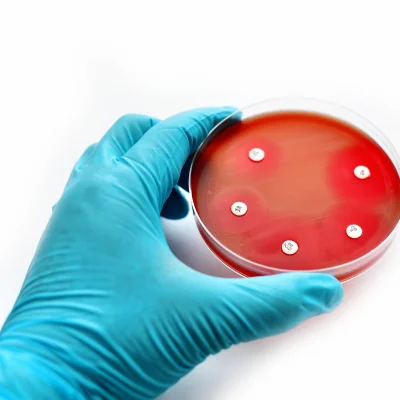

- 2/6, FF, Sarvpriya Vihar, Delhi: 110017
- Mon – Sun: 9.00 am – 8.00pm
VetSERV closely collaborates with veterinary practitioners. Our Veterinary professionals work closely with all demanding clinics – through periodic feedback sessions and implementing 100% of their suggestions. We tailor our suggestions based on what works best for the Vets and their patients. For e.g., we know that most veterinary clinics work in the mornings as well as in the evevning. Accordingly, we service all our vets at least twice a day.

Testing a pet’s blood is the most basic test that vets prescribe and allows for a variety of inferences. Most labs run this test on an automatic machine and report the results as is.
At VetSERV, we understand how crucial it is to get:
– The platelet count just right – in all diseases, collectively called – “tick fever”, platelet count is the key indicator that vets rely on for diagnosis. We understand how crucial this is.
At VetSERV, we examine 100% of blood samples under a microscope – so that what we report is as accurate as it can get for the vet to take correct treatment decisions.
Before treating local infections such as an Ear infection, urinary tract infection or an old wound, most competent vets go in for culture and sensitivity testing.
This allows a vet to:
– understand better the nature of infection
– choose the most appropriate antibiotic
At VetSERV, while carrying out sensitivity testing, We
use more number of antibiotics than any other lab to give the vet a wider choice
– use antibiotics that are more relevant to veterinary practice
– unlike other labs which rely on antibiotics used commonly for humans.
VetSERV’s sensitivity testing allows vets to choose the right antibiotic – especially in difficult to treat and cases of recurring infections.
VetSERV is the only lab to include veterinary relevant antibiotics in sensitivity testing

VetSERV is a specialist veterinary lab – we specialise in identifying bugs that affect animals under a microscope in your pet’s blood and other samples.
Our experts know what a blood parasite like Ehrlichia canis or Hepatozoon canis looks like or if your pet’s tummy is infected with Ancylostoma or Giardia or Coccidia or Toxocara or Spirocerca.
Expertise in knowing how blood cell shapes and sizes differ under microscope for cats, dogs, sheet, camels, horses etc. means a different level of accuracy in reporting
When your pet’s blood goes under microscope at VetSERV, we know a dog’s blood from cat’s blood – we know how a sheep’s blood cells and a camel’s blood cells are unique.
Our veterinary experts know their bloodwork so well – adding accuracy and credibility to your pet’s sample
